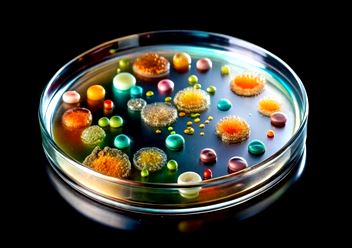

IMPLEMENTATION OF PARETO PRINCIPLE IN IDENTIFICATION PROGRAM OF BACTERIAL ISOLATES IN HEALTHCARE ENVIRONMENT
Keywords:
disinfectant validation, healthcare-associated infections, Micrococcus spp., Pareto principle, Pseudomonas spp.Abstract
Background and aims: Healthcare associated infections are a major concern, causing an estimated 72,000 deaths and costing the United States up to $45 billion annually. This study aimed to identify and characterize bacterial isolates in healthcare facilities to improve infection control.
Methods: Using biochemical identification and Pareto analysis, samples were examined to determine the most prevalent bacterial species. The Pareto principle helped focus efforts on the major contaminants.
Results: Results showed that Pseudomonas genus (34.6%) and Micrococcus genus (19.2%) were the most abundant, accounting for more than 50% of isolates. The presence of multiple bacterial species, including both Gram-positive and Gram-negative bacteria, suggests widespread prevalence, likely a result of inadequate cleaning and contamination of water or surfaces. Gram-positive bacilli were less common due to their lower environmental resistance.
Conclusions: The study concluded that implementing proper cleaning and disinfection protocols and regularly monitoring water quality are essential for preventing cross-infection and ensuring a safe environment. Identifying the most prevalent bacteria using the Pareto principle is a crucial step in mitigating the risk of microbial contamination.
Peer Review History:
Received 8 August 2025; Reviewed 11 September 2025; Accepted 19 October; Available online 15 November 2025
Academic Editor: Dr. Emmanuel O. Olorunsola , Department of Pharmaceutics & Pharmaceutical Technology, University of Uyo, Nigeria, [email protected]
, Department of Pharmaceutics & Pharmaceutical Technology, University of Uyo, Nigeria, [email protected]
Reviewers:
 Prof. Hassan A.H. Al-Shamahy, Sana'a University, Yemen, [email protected]
Prof. Hassan A.H. Al-Shamahy, Sana'a University, Yemen, [email protected]
 Dr. Mohaddese Mahboubi, Alzahra University, Tehran, Iran, [email protected]
Dr. Mohaddese Mahboubi, Alzahra University, Tehran, Iran, [email protected]
Downloads

Published
How to Cite
Issue
Section
Copyright (c) 2025 Universal Journal of Pharmaceutical Research

This work is licensed under a Creative Commons Attribution-NonCommercial 4.0 International License.









 .
.